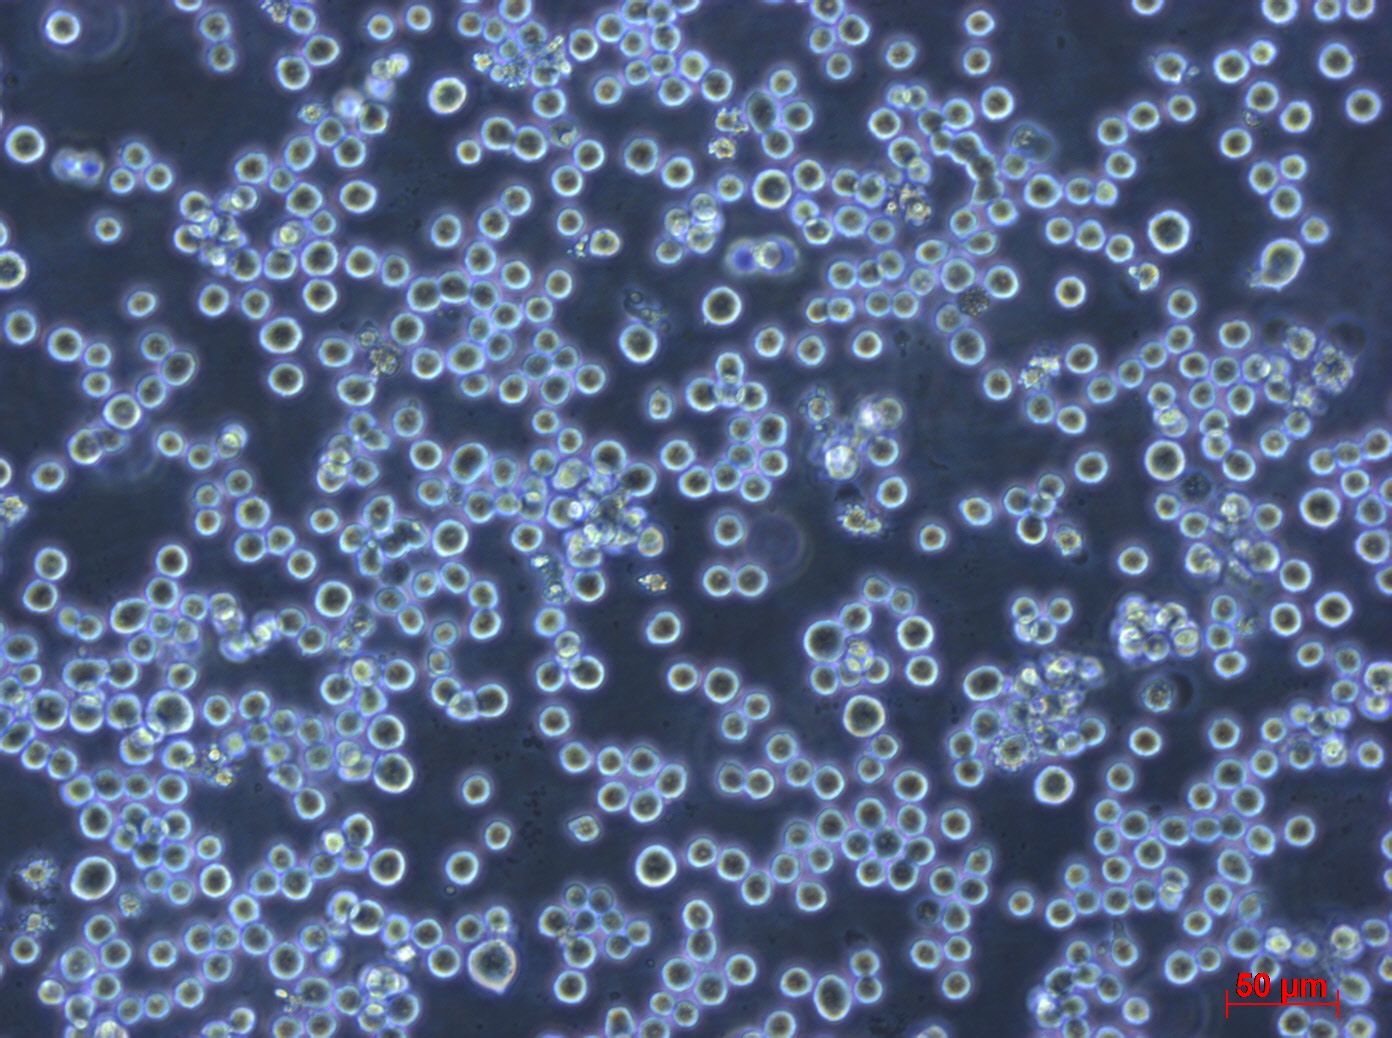
产品细节图片2

相关产品推荐更多 >
万千商家帮你免费找货
0 人在求购买到急需产品
- 详细信息
- 文献和实验
- 技术资料
- 英文名:
RPMI-8226,RPMI 8226; RPMI.8226; RPMI8226; RPMI no. 8226; RPMI no 8226; RPMI #8226; 8226; RPMI 8226/S; RPMI-8226S; RPMI8226/S; 8226/S; Roswell Park Memorial Institute 8226; GM02132; GM2132; GM 2132; GM02132C;
- 库存:
1×10^6
- 供应商:
澳音生物
- 肿瘤类型:
--
- 细胞类型:
B淋巴细胞
- 品系:
61岁,男
- 组织来源:
外周血
- 相关疾病:
多发性骨髓瘤
- 物种来源:
人
- 免疫类型:
--
- 细胞形态:
淋巴母细胞样
- 是否是肿瘤细胞:
是
- 器官来源:
外周血
- 运输方式:
复苏发货或干冰冷冻发货
- 年限:
---
- 生长状态:
悬浮
- 规格:
T25
以上产品图片均为本公司细胞出入库时拍摄
培养条件:
培养基:RPMI-1640 90%,优质胎牛血清,10%
气相:空气,95%; 二氧化碳(CO 2),5%
温度:37°C
STR信息:

BCRC参考图:

收到货后处理方式: 1.细胞冻存管: 收到货物后,请检查箱子里面是否还有干冰。 ● 若干冰已剩余不多,不能掩埋冻存管,请及时拍照,并第一时间联系销售。 ● 若干冰充裕,可以安排复苏细胞,复苏方法参考【说明书】;不安排复苏,请将细胞冻存管转移到液氮进行保存。短期(一周内)的存放可以放在-80冰箱,建议最好保存在液氮中。 2.培养瓶的活细胞: 收到请检查培养瓶是否完好,是否有漏液,培养基是否浑浊 ●若出现以上问题请于当天和我们销售取得联系,我们会第一时间为您处理。 ● 若以上问题都没有出现:拆掉培养瓶的外包装,在显微镜下对细胞进行多个视野,不同倍镜拍照。然后用酒精对瓶身进行彻底消毒,放在37度二氧化碳培养箱中进行复温。1-2小时后,拿出在显微镜下观察,并进行多个视野不同倍镜拍照。若细胞达到了可以传代的密度,请按照【说明书】的传代方法进行操作。若细胞密度不能进行传代,请回收培养瓶中的培养基,留适量培养基在瓶中,并将培养瓶放在培养箱继续培养即可(个别细胞除外,详见说明书)
仅供研究之用
联系我们:


风险提示:丁香通仅作为第三方平台,为商家信息发布提供平台空间。用户咨询产品时请注意保护个人信息及财产安全,合理判断,谨慎选购商品,商家和用户对交易行为负责。对于医疗器械类产品,请先查证核实企业经营资质和医疗器械产品注册证情况。
 文献和实验
文献和实验相关专题 在实验中我们经常会需要自己配置RPMI1640培养基,在配置的过程中需要注意哪些?哪些因素会影响到RPMI1640培养基的配置效果呢?生物帮为您盘点 了配制RPMI1640培养基13点需知,详情请看下文: 1)配制培养基最好使用新制备的三蒸水。一般在试验前当天或前一天制备为好。调节pH值的酸碱溶液也应该使用这种水配制。 2)培养液配好后,应先抽取少许放入培养瓶内,于37℃温箱内置24~48hr
1) 配制培养基最好使用新制备的三蒸水。一般在试验前当天或前一天制备为好。调节pH值的酸碱溶液也应该使用这种水配制。 2) 制备培养基的器皿清洗要绝对干净,烤干后备用(滤器、滤膜、量筒、移液管及盛放培养基的小瓶等存放和转移培养基液体的器具都应进行灭菌)。 3) 溶解培养基:将干粉培养基溶于总量1/3的水中,再用水洗包装袋内面两次,倒入培养液中。振荡
相关专题 细胞培养基的配制 细胞培养专题 MEM细胞培养基 关于RPMI 1640细胞培养 液的配制 1) 配制培养基最好使用新制备的三蒸水。一般在试验前当天或前一天制备为好。调节pH值的酸碱溶液也应该使用这种水配制。 2) 制备培养基的器皿清洗要绝对干净,烤干后备用(滤器 、滤膜、量筒、移液管及盛放培养基的小瓶等存放和转移培养基液体的器具都应进行灭菌)。 3) 溶解培养基:将干粉培养基溶于总量





![WPMY-1[ WPMY1] 正常前列腺基质永生化细胞](https://img1.dxycdn.com/2020/0209/390/3395660348241064603-14.jpg!wh200)
![TCCSUP[ TCCSuP; TCC-SUP; TCC Sup]膀胱癌细胞](https://img1.dxycdn.com/2020/0326/118/3404247740212206187-14.jpg!wh200)

![NCI-H520[H520; H-520; NCI-HUT-520; NCIH520]肺鳞癌细胞](https://img1.dxycdn.com/2020/0412/776/3407358247869935092-14.jpg!wh200)

